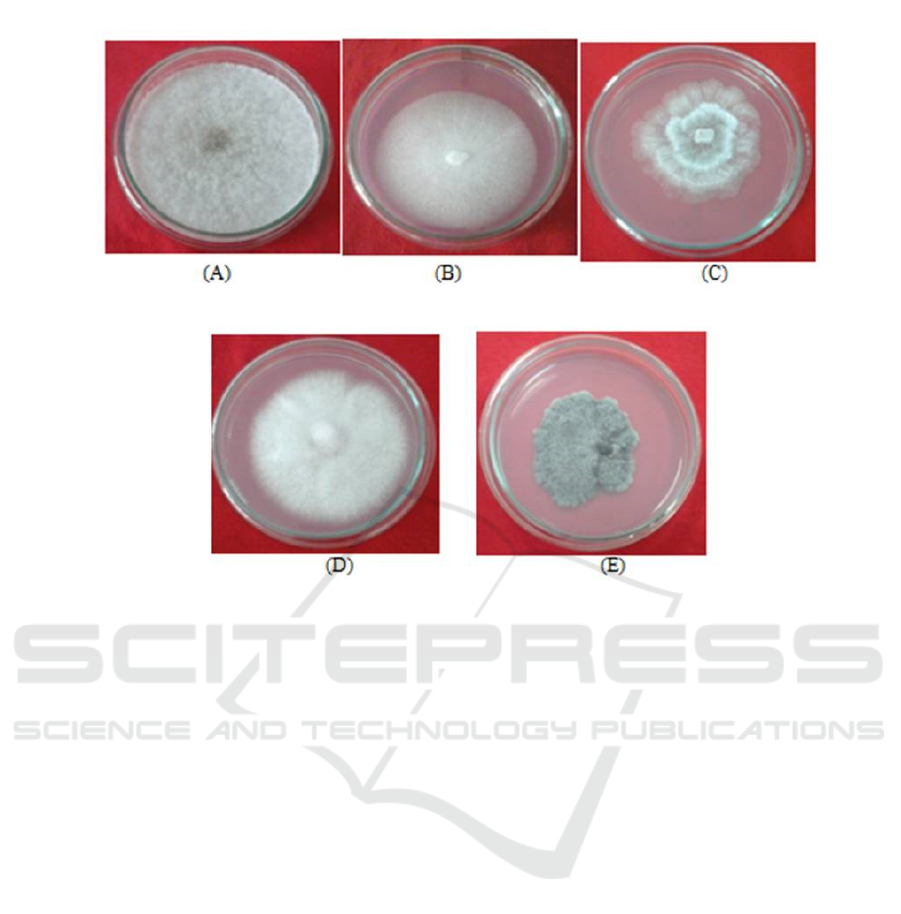

The Alpha-Amylase Inhibition Potential of Endophytic Fungi from
Indonesian Bay Leaves (Eugenia polyantha WIGHT.)
Wahyu Hidayati, Ade Nur Padillah, Maharadingga, Ni Putu Ermi Hikmawanti, Rini Prastiwi, Ani
Pratiwi, Lady Farahmayuni, Rezza Syahputra, Muhammad Fahrul
Faculty of Pharmacy and Sciences, Universitas Muhammadiyah Prof. DR. HAMKA, Jakarta Timur, Indonesia
Keywords: Eugenia polyantha, Endophytic fungi, Antidiabetic, Alpha-amylase, Inhibition, Diabetes
Abstract: Indonesian people use bay leaves as spices in local culinary and as traditional medicine, particularly to treat
diabetes. The problems with the mass production of antidiabetic drugs from bay leaves can be solved by
utilizing endophytic fungi as an alternative source for antidiabetic compounds. This study aimed to isolate
endophytic fungi from bay leaves and identify their antidiabetic activity through the in vitro inhibition of
alpha-amylase. The leaves were processed on potato dextrose agar media, and five isolates were grown in
an agar medium. The fermentation used a potato dextrose yeast medium that was left for five days on an
orbital shaker at room temperature. The crude was extracted using ethyl acetate solvent. In the in vitro
alpha-amylase inhibition test, the antidiabetic assay used the ethyl acetate extract of the endophytic fungi.
The inhibition percentage was calculated from the absorbance value read by a microplate reader. All isolates
inhibited alpha-amylase activity, but only three of them had high inhibition percentages (14.385%,
12.849%, and 39.246%). As a conclusion, the endophytic fungi isolated from bay leaves are potential as an
alternative source for the production of secondary metabolites to cure diabetes.
1 INTRODUCTION
Eugenia polyantha WIGHT. is one of the plants in
Indonesia that are commonly used as spices in many
local dishes. Empirically, this plant, especially the
leaf, has been widely used as medicine since the
ancient time. People believe that the leaves can cure
some diseases, including diabetes (Aminov, 2010;
Lelono & Tachibana, 2013; Elya et al., 2015;
Murugan et al., 2017).
Diabetes is a chronic disease caused by
insufficient production of insulin hormones by the
pancreas. It is characterized by the elevation of
blood sugar in the body. It can trigger some chronic
metabolite syndromes, such as cardiovascular
diseases and kidney disorders. According to the
statistical data reported by World Health
Organization (2016), in 2012, diabetes directly
caused 1.5 million deaths, and another 2.2 million
deaths were caused by diabetes-related diseases,
such as cardiovascular and kidney disorders.
Furthermore, in 2014, an estimated 422 million
adults over 18 years of age world wide had diabetes.
The Indonesian Ministry of Health reports that 12
million people in Indonesia have diabetes.
Moreover, WHO reveals a slight increase in the
number of diabetic people in Indonesia from 1996 to
2014 (WHO, 2016).
There are several preventive and curative ways
to reduce the number of diabetic people. For
prevention, WHO designs early detection methods,
such as blood glucose measurements, oral glucose
measurements, and HbA1c test. This organization
also introduces new preventive methods, namely
telemedicine and mobile phone-assisted intervention
to reach remote areas. In 2014, the government of
Senegal launched a diabetes monitor application
called mRamadan, which received support from
WHO. This approach improves the diabetes
management in remote areas. Besides prevention,
diabetes requires treatments that focus on the
reduction of blood glucose level. Some of the
commonly used medicines are insulin (by injection
or oral administration), metformin, glibenclamide,
and sulfonylurea (Serrano-Cinca et al., 2005; WHO,
2016).
Nowadays, people still believe that plants can be
used as alternative medicines. As the results, bay
leaves remain as an alternative source to cure
diabetes. The high price of antidiabetic medicines
Hidayati, W., Padillah, A., Maharadingga, ., Hikmawanti, N., Prastiwi, R., Pratiwi, A., Farahmayuni, L., Syahputra, R. and Fahrul, M.
The Alpha-Amylase Inhibition Potential of Endophytic Fungi from Indonesian Bay Leaves (Eugenia polyantha WIGHT.).
DOI: 10.5220/0008240201070111
In Proceedings of the 1st Muhammadiyah International Conference on Health and Pharmaceutical Development (MICH-PhD 2018), pages 107-111
ISBN: 978-989-758-349-0
Copyright
c
2021 by SCITEPRESS – Science and Technology Publications, Lda. All rights reserved
107

contributes to this preference. Most of them are not
affordable for some people from low- to middle-
income families, limiting their options to herbal
medicines. The high expectation of the therapeutic
benefits of bay leaves triggers herbal medicine
companies to commercialize any drugs made of bay
leaves. However, they have to face a major obstacle,
that is finding the area to plant E. polyantha
WIGHT. The utilization of microbes in the
production of metabolites to cure diabetes
experiences a corresponding situation. The
potentially explorable microbes, in this case, are
endophytes. Endophytes are groups of microbes that
live inside plant tissue and have a symbiotic
relationship with the plants. They are also
responsible in the biosynthesis of secondary
metabolitesin the host plants (Strobel & Daisy 2003;
Staniek et al., 2008; Mishra et al., 2014; Pimentel et
al., 2011).
Based on the previous information, this study
aimed to investigate the potential of endophytic
fungi for producing secondary metabolites that could
inhibit alpha-amylase.
2 MATERIALS AND METHOD
2.1 Materials
This study used fresh bay leaves from Bekasi, West
Java, Indonesia. It also used some media and
reagents for the experiments. The endophytic fungi
isolation used 70% ethanol, 5.3% NaOAc,
Chloramphenicol (Generik, Indonesia), Potato
Dextrose Agar or PDA (Merck, USA), aquadest.
The Potato Dextrose Yeast or PDY (Merck, USA)
and ethyl acetate solvents were also used for the
fermentation and extraction process. As for the
alpha-amylase inhibition assay, the materials were
alpha-amylase enzyme from Bacillus sp. (Sigma-
Aldrich, USA), Phosphate Buffer Saline or PBS
(Sigma-Aldrich, USA), soluble starch (Sigma-
Aldrich, USA), acarbose (Generik, Indonesia), and
the Lugol’s reagent.
2.2 Methods
This study consist of several steps, namely
endophytic fungi isolation, fermentation and
secondary metabolites extraction, and alpha-amylase
inhibition assay as the last procedure.
2.2.1 Endophytic Fungi Isolation
This step began with leaf surface sterilization as
described in Widowati et al. (2016). The sterilized
leaves were then cut into several pieces (1 cm x 1
cm), put into a sterile PDA medium, and incubated
at room temperature for seven days.
2.2.2 The Fermentation and Extraction of
Secondary Metabolites
The fermentation was based on the protocol
introduced by Suciatmih et al. (2011) with some
modifications. Two pieces of endophyte isolates (1
cm x1 cm) were added to 20 ml of PDY medium and
incubated in a shaking incubator at room
temperature for seven days at 170 rpm. Afterward,
the metabolites were harvested by extracting the
fermented medium. The extraction involved the
addition of 1 volume of ethyl acetate into the
fermented medium that had already separated from
mycelium. The extract was then dissolved in PBS
for 500 ppm dosage.
2.2.3 The Inhibitory Activity of Alpha-
Amylase Assay
This process followed the inhibition assay for alpha-
amylase described in Kellogg et al. (2014). It used
the extract as the samples, acarbose as the positive
control, the uninhibited enzyme as the negative
control, and the extracts or acarbose without enzyme
as blanks. For the samples and the positive control,
this research used 96-well plate filled with 35 ul of
the extract or acarbose and 5 ul of the starch
substrate. The plates were then incubated at 37
0
C for
5 min. Afterward, 10 ul of the alpha-amylase
enzyme solution was added to each well and
incubated at 37
0
C for 10 min. The addition of 150 ul
of Lugol’s solution to each well would stop the
reaction. Then, the inhibition percentage was
calculated according to the absorbance value read by
a microplate reader at a wavelength of 595 nm. The
calculation of the inhibitory activity of each sample
used the formula (1)
% ℎ
=
−(
−
)
100%
(1)
A
con
is the absorbance of the uninhibited enzyme,
A
ext
is the absorbance of the enzyme treated with the
extract, and A
blank
is the absorbance of the extract
with the substrate (no presence of enzyme).
MICH-PhD 2018 - 1st Muhammadiyah International Conference on Health and Pharmaceutical Development
108
2.2.4 Data Analysis
The analysis results were the average value (in
mean±SD) of the triplicate assay.
3 RESULTS AND DISCUSSION
The term endophyte defines the community of
microbes living inside plant tissue without damaging
their host. These organisms are reported to be
responsible for the secondary metabolic biosynthesis
of their host plants (Strobel & Daisy 2003; Strobel
2006; Staniek et al., 2008; Alvin et al., 2014; Zhang
et al., 2012). Therefore, the microbes produce some
compounds that can be found in the host plants (Qiu
et al., 2015; Zhang et al., 2012; Tan & Zou 2001).
The isolation of microbes from their host is the
most difficult procedure in endophyte research due
to the risk of contamination. As a preventive
measure, some antibiotics were introduced to the
isolation medium. This study used Chloramphenicol
to inhibit the presentation of bacteria. The isolation
commenced with placing the part of the plants’
organ on the agar medium. Afterward, this medium
was incubated for several days. This research
obtained five endophytic fungi after seven days of
incubation (Figure. 1).
The secondary metabolites were cultivated in a
liquid medium using the liquid fermentation method.
The harvested metabolites were collected through
ethyl acetate extraction. This study used ethyl
acetate instead of other solvents because the
targetted compounds were flavonoids. The other
reason for choosing the solvent was polarity. Ethyl
acetate is a semipolar solvent, meaning that it
attracts polar to semi-polar metabolites (Haque et
al., 2005). Flavonoid is polar and, therefore,
removable by ethyl acetate.
The antidiabetic activity of extracts from plants
or microbes can be measured in vitro and in vivo.
There are two types of assay commonly used in in
vitro experiments, namely β-glucosidase and α-
amylase inhibition. Analyzing the inhibition of these
enzymes is necessarybecause they induce the
absorption of glucose and the associated
postprandial hyperglycemic spike (Kellogg et al.,
2014; Sahani et al., 2017; Ruzieva et al., 2017).
Such inhibition is a strategy in diabetes management
as it can control the serum glucose level.
Figure 1. The isolates of endophytic fungi from Indonesian bay leaves: (A) KSP-O1, (B) KSP-02, (C) KSP-03, (D)
KSP-04, and (E) KSP-05
The Alpha-Amylase Inhibition Potential of Endophytic Fungi from Indonesian Bay Leaves (Eugenia polyantha WIGHT.)
109

This study only performed the inhibition assay
for alpha-amylase. Alpha-amylase is an enzyme that
hydrolyzes carbohydrate into glucose, and in
advance, it is easily absorbable (Kellogg et al.,
2014). Most of this enzyme is present in saliva, and,
as aconsequence, the serum glucose level becomes
higher easily because the hydrolyzation of
carbohydrate already begins in the mouth (Sahani et
al., 2017). The inhibitio n of alpha-amylase activity
decelerates the conversion of starch into glucose and
effectively reduces glucose absorption (Ruzieva et
al., 2017; Sahani et al., 2017). Based on the data
presented in Ta ble 1, each isolate of the endophytic
fungi inhibited the enzyme at different rates. Among
the five isolates, KSP-4 had the lowest activity. On
the contrary, KSP-5 had the highest percentage of
inhibitory activity, but it was lower than acarbose
(Figure.2).
4 CONCLUSIONS
Nowadays, endophytes become increasingly
attractive to observe particularly due to the difficulty
of finding a large area to grow medicinal host plants
for product commercialization. One of the chronic
diseases that causes high amount of mortality is
diabetes. Diabetes can be handled with prevention
and medication. Reducing blood glucose level is the
effective management in increasing the survival rate
of diabetic people. This study showed that the
endophytic fungi from one of the Indonesian
medicinal plants could inhibit the activity of alpha-
amylase. Further investigation is needed to optimize
the extraction to obtain the lowest concentration
with the greatest inhibitory activity and to identify
the in vitro inhibitory ability of endophytic fungi
against the alpha-glucosidase enzyme.
REFERENCES
Alvin, A., Miller, K. I., & Neilan, B. A. (2014). Exploring
the potential of endophytes from medicinal plants as
sources of antimycobacterial compounds.
Microbiological Research, 169(7–8), 483–495.
http://doi.org/10.1016/j.micres.2013.12.009
Aminov, R. I. (2010). A brief history of the antibiotic era:
Lessons learned and challenges for the future.
Frontiers in Microbiology, 1(DEC), 1–7.
http://doi.org/10.3389/fmicb.2010.00134
Elya, B., Handayani, R., Sauriasari, R., Azizahwati, A.,
Hasyyati, U. S., Permana, I. T., & Indah, P. Y. (2015).
Antidiabetic Activity and Phytochemical Screening of
Extracts from Indonesian Plants by Inhibition of Alpha
Figure 2. The Graphic of the Alpha-Amylase Inhibitory Activity (%) of Endophytic Fungi Isolated from the Indonesian
Bay Leaves and Acarbose
Table 1. The Alpha-amylase Inhibitory Potential (%
Control) of Endophytic Fungi Crude Extract and
Acarbose
Samples
Percentage of inhibition
(% ± SD)
KSP-01 14.38 ± 1,95
KSP-02 12.85 ± 3,91
KSP-03 6,94 ± 5,38
KSP-04 4,42 ± 2,51
KSP-05 39,24 ± 3,28
Acarbose 46.50 ±1.42
MICH-PhD 2018 - 1st Muhammadiyah International Conference on Health and Pharmaceutical Development
110

Amylase, Alpha Glucosidase and Dipeptidyl Peptidase
IV. Pakistan Journal of Biological Sciences, 18(6),
279–284. http://doi.org/10.3923/pjbs.2015.279.284
Haque, M. A., Hossain, M. S., Rahman, M., Rahman, M.
R., Hossain, M. S., Mosihuzzaman, M., … Khan, S.
(2005). Isolation of Bioactive Secondary Metabolites
from the Endophytic Fungus of Ocimum basilicum.
Dhaka University Journal of Pharmaceutical
Sciences, 4(2), 127–130.
http://doi.org/10.3329/dujps.v4i2.215
Kellogg, J., Grace, M. H., & Lila, M. A. (2014).
Phlorotannins from Alaskan Seaweed Inhibit
Carbolytic Enzyme Activity, 5277–5294.
http://doi.org/10.3390/md12105277
Lelono, R. A. A., & Tachibana, S. (2013). Preliminary
Studies of Indonesian Eugenia polyantha Leaf
Extracts as Inhibitory of Key Enzymes for Type 2
Diabetes. Journal of Medical Sciences, 2, 103–110.
http://doi.org/10.392/jms.2013.103.110
Mishra, Y., Singh, A., Batra, A., & Sharma, M. M. (2014).
Microbial & Biochemical Technology Understanding
the Biodiversity and Biological Applications of
Endophytic Fungi: A Review.
http://doi.org/10.4172/1948-5948.S8-004
Murugan, K. K., Poojari, C. C., Ryavalad, C.,
Lakshmikantha, R. Y., Satwadi, P. R., Vittal, R. R., &
Melappa, G. (2017). Anti-diabetic Activity of
Endophytic Fungi, Penicillium Species of Tabebuia
argentea; in Silico and Experimental Analysis.
Research Journal of Phytochemistry, 11(2), 90–110.
http://doi.org/10.3923/rjphyto.2017.90.110
Pimentel, M. R., Molina, G., Dion, A. P., & Pastore, M.
(2011). The Use of Endophytes to Obtain Bioactive
Compounds and Their Application in
Biotransformation Process, 2011.
http://doi.org/10.4061/2011/576286
Qiu, M., Xie, R., Shi, Y., Zhang, H., & Chen, H. (2015).
Isolation and identification of two flavonoid-
producing endophytic fungi from Ginkgo biloba
Isolation and identification of two flavonoid-
producing endophytic fungi from Ginkgo biloba L.,
(MARCH 2010). http://doi.org/10.1007/s13213-010-
0016-5
Ruzieva, D. M., Abdulmyanova, L. I., Rasulova, G. A.,
Sattarova, R. S., & Gulyamova, T. G. (2017).
Screening of Inhibitory Activity against α -Amylase of
Fungal Endophytes Isolated from Medicinal Plants in
Uzbekistan. International Journal of Current
Microbiology and Applied Sciences, 6(4), 2744–2752.
Sahani, K., Thakur, D., Hemalatha, K. P. J., & Ganguly,
A. (2017). Antiglycemic Activity of Endophytic Fungi
from Selected Medicinal Plants by Alpha-Amylase
Inhibition Method. International Journal of Science
and Research, 6(3), 2203–2206.
Serrano-Cinca, C., Fuertes-Callén, Y., & Mar-Molinero,
C. (2005). Measuring DEA efficiency in Internet
companies. Decision Support Systems, 38(4), 557–
573. http://doi.org/10.1016/j.dss.2003.08.004
Staniek, A., Woerdenbag, H. J., & Kayser, O. (2008).
Chapter 2 Endophytes exploiting biodiversity for the
improvement of natural product-based drug discovery.
Journal of Plant Interactions, 3, 75–98.
Strobel, G. (2006). Harnessing endophytes for industrial
microbiology. Current Opinion in Microbiology, 9,
240–244. http://doi.org/10.1016/j.mib.2006.04.001
Strobel, G., & Daisy, B. (2003). Bioprospecting for
Microbial Endophytes and Their Natural Products,
67(4), 491–502.
http://doi.org/10.1128/MMBR.67.4.491
Suciatmih, Yuliar, & Supriyati, D. (2011). Isolasi,
Identifikasi, dan Skrining Jamur Endofit Penghasil
Agen biokontrol dari Tanaman di Lahan Pertanian dan
Hutan Penunjang Gunung Salak. J. Tek. Ling, 12(2),
171–186.
Tan, R. X., & Zou, W. X. (2001). Endophytes: a rich
source od functional metabolites. Nat. Prod. Rep.,
18(4), 448–459. http://doi.org/10.1039/b100918o
WHO. Diabetes Country Profiles 2016 (2016). Retrieved
from http://www.who.int/diabetes/country-
profiles/idn_en.pdf
Widowati, T., Bustanussalam, Sukiman, H., &
Simanjuntak, P. (2016). Isolasi dan Identifikasi
Kapang Endofit Dari Tanaman Kunyit (Curcuma
longa L.) Sebagai Penghasil Antioksidan. Biopropal
Industri, 7(1), 9–16. Retrieved from
https://media.neliti.com/media/publications/53471-ID-
isolasi-dan-identifikasi-kapang-endofit.pdf
Zhang, Y., Han, T., Ming, Q., Wu, L., Rahman, K., & Qin,
L. (2012). Alkaloids produced by endophytic fungi: A
review. Natural Product Communications, 7(7).
The Alpha-Amylase Inhibition Potential of Endophytic Fungi from Indonesian Bay Leaves (Eugenia polyantha WIGHT.)
111
